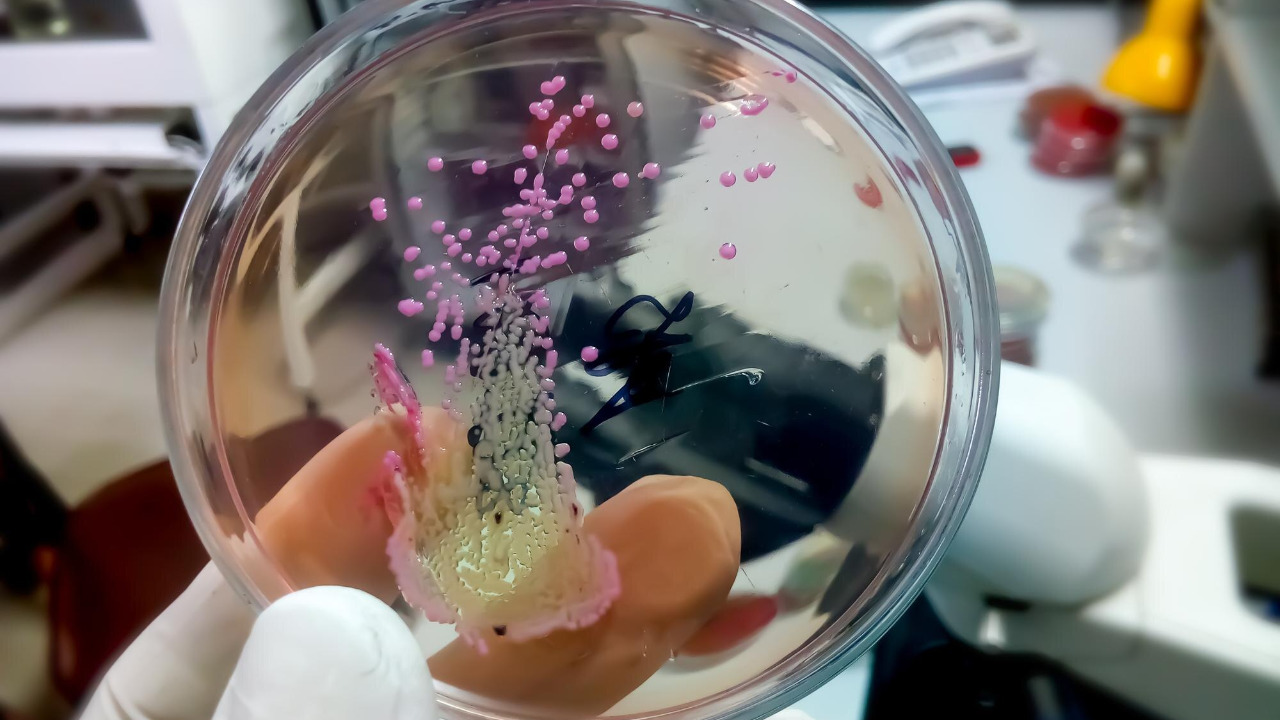

Life’s leap from single-celled to multicellular organisms marks a pivotal moment in evolutionary history. This transformation laid the foundation for the complex life forms we see today. By studying simple organisms that still exist in similar forms, scientists are piecing together the mysteries of this monumental transition.
The Origins of Multicellularity

The journey from single-celled to multicellular life forms began over a billion years ago, as evidenced by fossil records and genetic studies. One of the earliest known multicellular organisms is a fossilized algae, called Bangiomorpha, dating back approximately 1.2 billion years. These early examples of multicellular life provide invaluable insights into how life on Earth began to diversify and evolve into complex structures. Genetic studies, such as those involving DNA sequencing, have revealed that certain genes crucial for multicellularity were present in these ancient organisms, indicating that the groundwork for complex life was laid much earlier than previously thought.
Environmental pressures played a significant role in promoting the development of multicellular organisms. As conditions on Earth changed, organisms were forced to adapt in order to survive. This adaptation often led to the aggregation of single cells into larger clusters, which eventually evolved into fully functioning multicellular organisms. The significance of cell specialization cannot be overstated, as it allowed for greater efficiency and adaptability. Cells within multicellular organisms began to specialize and perform specific roles, leading to the development of tissues and organs—a hallmark of complex life.
Key Models in Study

Volvox, a type of green algae, serves as an important model for understanding the evolution of multicellularity. This simple organism is a colonial green algae that forms spherical colonies composed of up to 50,000 cells. By studying Volvox, scientists have been able to identify key genetic and developmental changes that facilitated the transition from single-celled to multicellular life. The insights gained from Volvox highlight the simplicity and elegance of nature’s solutions to complex biological challenges.
Another fascinating organism is Dictyostelium discoideum, commonly known as the social amoeba. This organism demonstrates how cooperation among individual cells can lead to complex multicellular structures. Under nutrient-rich conditions, Dictyostelium exists as single-celled amoebas. However, when resources become scarce, these cells aggregate to form a multicellular slug-like structure. This ability to switch between unicellular and multicellular states provides a unique perspective on how multicellular life forms could have evolved under varying environmental conditions.
Choanoflagellates, the closest living relatives of animals, offer another important model for studying multicellularity. These single-celled organisms possess features that are remarkably similar to the cells found in sponges, the simplest form of animal life. By examining choanoflagellates, researchers can infer what our early multicellular ancestors might have looked like and how they functioned. The study of choanoflagellates provides valuable insights into the origins of animals and the evolutionary processes that led to the diversity of life on Earth.
Mechanisms and Processes

At the genetic level, the transition to multicellularity involved a series of complex changes. Alterations in DNA sequences enabled cells to communicate and cooperate more effectively, laying the foundation for multicellular life. Key molecular mechanisms, such as gene duplication and the evolution of new gene functions, played a pivotal role in this evolutionary leap. These genetic innovations provided the necessary tools for cells to specialize and take on distinct roles within an organism.
The evolution of communication and cooperation among cells was crucial for the development of multicellular organisms. Signaling pathways, which allow cells to transmit and receive information, evolved to facilitate coordination among cells. These pathways enabled cells to work together harmoniously, leading to the formation of complex structures and functions. The ability to communicate and cooperate effectively is one of the defining characteristics of multicellular life.
Reproductive strategies also underwent significant changes during the transition to multicellularity. Multicellular reproduction brought about new ways of ensuring survival and genetic diversity. For example, the development of specialized reproductive cells, such as sperm and eggs, allowed for more efficient and varied reproduction. This, in turn, contributed to the success and proliferation of multicellular organisms.
Challenges and Controversies

The evolution of multicellularity is a topic rife with debates among scientists. There are multiple theories on how and why this transition occurred. Some researchers argue that multicellularity arose due to environmental pressures, while others believe it was driven by genetic innovations. These differing perspectives highlight the complexity of tracing back evolutionary history and understanding the factors that contributed to this monumental leap.
Reconstructing evolutionary history is inherently challenging due to the difficulties in tracing genetic and fossil evidence. The fossil record is often incomplete, and genetic data can be difficult to interpret. Despite these challenges, advances in technology and research methods continue to shed light on the origins of multicellularity. Modern research on simple organisms, such as Volvox and Dictyostelium, challenges existing theories and provides new insights into this evolutionary milestone.
The implications of studying the evolution of multicellularity extend beyond understanding ancient life forms. Current research has the potential to inform our understanding of human evolution and the development of complex life. By examining the genetic and environmental factors that contributed to the emergence of multicellular organisms, scientists can gain valuable insights into the broader processes of evolution that have shaped life on Earth.
Implications for Understanding Evolution
The study of multicellularity has broad implications for our understanding of evolutionary processes. By examining the transition from single-celled to multicellular life, researchers can gain insights into the mechanisms that drive evolutionary change. These insights have the potential to inform our understanding of how complex life forms, including humans, have evolved over millions of years.
Understanding the origins of multicellularity also provides valuable insights into human evolution. By studying the genetic and environmental factors that contributed to the emergence of multicellular organisms, scientists can better understand our own evolutionary history. This research has the potential to reveal important information about the development of human traits and characteristics that distinguish us from other life forms.
Future research directions in the study of multicellularity are vast and varied. Potential areas of study include further exploration of the genetic and molecular mechanisms that facilitated the transition to multicellular life, as well as the environmental factors that drove this evolutionary leap. By continuing to study simple organisms and their complex behaviors, researchers can further illuminate the path from single-celled to complex life and enhance our understanding of the evolutionary processes that have shaped life on Earth.